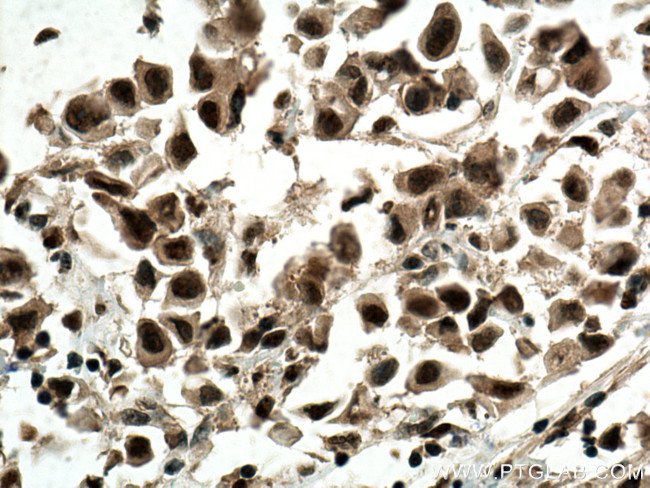
CDK4 Antibody in Immunohistochemistry (Paraffin) (IHC (P))

Search
Proteintech
CDK4 Monoclonal Antibody (1G2C12)
{{$productOrderCtrl.translations['antibody.pdp.commerceCard.promotion.promotions']}}
{{$productOrderCtrl.translations['antibody.pdp.commerceCard.promotion.viewpromo']}}
{{$productOrderCtrl.translations['antibody.pdp.commerceCard.promotion.promocode']}}: {{promo.promoCode}} {{promo.promoTitle}} {{promo.promoDescription}}. {{$productOrderCtrl.translations['antibody.pdp.commerceCard.promotion.learnmore']}}
产品信息
66950-1-IG
种属反应
已发表种属
宿主/亚型
分类
类型
克隆号
抗原
偶联物
形式
浓度
规格
纯化类型
保存液
内含物
保存条件
运输条件
产品详细信息
Aliquoting is unnecessary for -20°C storage.
靶标信息
CDK4/cyclin D3 serine/threonine kinase is dimeric protein complex. CDK4 is a member of the cyclin-dependent protein kinase family and is involved in the control of cell proliferation during the G1 phase of cell cycle. CDK4 forms a complex with the D-type cyclins and is inhibited by p16 (cyclin-dependent kinase inhibitor-2). CDK4 can mediate phosphorylation of the C-terminal region of Rb protein leading to an active transcriptional repression of E2F complex. CDC37 and HSP90 can preferentially associate with the fraction of CDK4 not bound to D-type cyclins. SMAD3 is a major physiologic substrate of the G1 cyclin-dependent kinases CDK4 and CDK2. Although CDK6 and CDK4 can both phosphorylate multiple residues in the Rb protein, they do so with different residue selectivity in vitro; CDK6 phosphorylates Thr821 while CDK4 phosphorylates Thr826 on Rb protein.
仅用于科研。不用于诊断过程。未经明确授权不得转售。
生物信息学
蛋白别名:
CDK4; Cell division protein kinase 4; CRK3; cyclin dependent kinase 4; Cyclin-dependent kinase 4; MGC14458; orf; p34
基因别名: CDK4; CMM3; Crk3; PSK-J3
UniProt ID: (Human) P11802, (Rat) P35426, (Mouse) P30285
Entrez Gene ID: (Human) 1019, (Rat) 94201, (Mouse) 12567